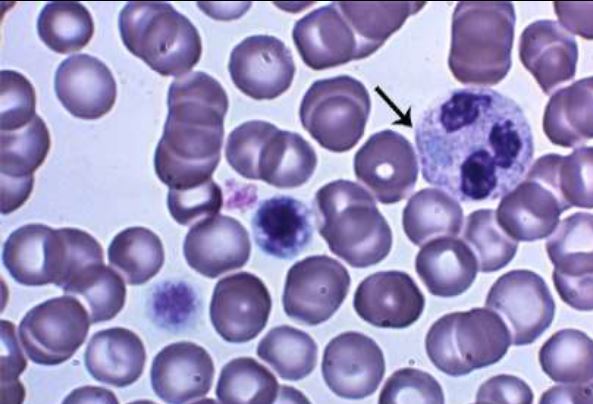

What does vWF bind to on the platelets?
Glycoprotein Ib/V/IX
(“1B59”)
Damanged endothelium–>circulating vWF in plasma attaches to endothelium, platelets attach to vWF using GPIb/V/IX
HIGH YIELD!
Platelets have alpha granules and delta (dense) granules. What do they contain?
*hint* dense only have 4 things whereas alpha has a lot so easiest to memorize contents of dense granule
Dense Granule:
- ADP dense granule which causes vasoconstriction
- ATP
- Serotonin
- Ca++
Alpha Granule:
- thromboglobulin
- P-selectin
- PDGF
- PF4
- platelet fibrinogen
- thrombospondin
- VWF
After vWF attaches to endothelium and platelets, platelets release their granules and change shape with expose their fibrinogen receptors. What receptor binds fibrinogen? What drugs inhibit this receptor?
Glycoprotein IIb/IIIa
GPIIbIIIa inhibitors: Abciximab-Reopro, Integrilin,
Aggrastat
Where is vWF made (two sites)?
Endothelial cells (Weibel-Palade bodies) and megakaryocytes (alpha granules)
Coagulation cascade is divided into intrinsic and extrinsic pathways based on in vitro methods. What activates these pathways?
- Intrinsic path activated by blood in contact with negative charged glass
- Extrinsic path activated by tissue factor (subendothelium)
What are the steps of fibrinolysis (breaking down clot)?
Tissue plasminogen activator (TPA) cleaves plasminogen to plasmin
Plasmin cleaves fibrin into fibrin split products
What are the there inhibitors of fibrinolysis?
- Alpha two antiplasmin inhibits plasmin
- PAI inhibits plasminogen
- TAFI (thrombin activatable fibrinolysis inhibitor)
inhibits binding of plasminogen and TPA to fibrin
How does protein C function?
Thrombomodulin binds to thrombin to activate protein C; with its carrier, protein S, activated protein C inhibits FV and FVIII
How does antithrombin function?
Liver-produced AT binds to heparin and inhibits conversion of II to IIa; also inhibits Xa action
Technically, how does the PTT test work?
• Method
– Take negatively charged surface phospholipid (partial thromboplastin)
– Add PPP + calcium chloride
– Measure the time to clot
- Normally < 40 seconds
- Measures intrinsic & common pathway
- Measures all factors except 7 and 13
Technically, how does the PT test work?
• Method
– Take tissue factor and phospholipids
– Add citrated patient’s platelet-poor plasma (PPP) & calcium chloride
– Measure the time to clot
• Normally < 15 seconds
• Measures the extrinsic and common pathways
Technically, how does the thrombin time work?
• Method
– Take exogenous thrombin
– Add PPP
– Measure time to clot
- Measures common pathway
- Measures conversion of fibrinogen to fibrin
• Doesn’t need Ca or phospholipid
• increased paraprotein, amyloid, heparin, dysfibrinogenemia
Technically, how does the reptilase time work?
• Method
– Take Bothrops atrox venom
– Add PPP
– Measure time to clot
• increased reptilase time in dysfibrinogenemia
• If patient is on heparin, they will have an increased TT but nl reptilase time
• Reptilase measures conversion of fibrinogen to fibrin, but is
insensitive to heparin
• heparinase + protamine will correct TT that is increased in a patient on heparin
Which factor inhibitor will correct with an immediate mixing study but then prolongs after 1-2 hours (time dependent prolongation)?
Factor VIII inhibitor
What happens in mixing studies with:
1) dysfibrinogenemia
2) hypofibrinogenemia
1) Partially corrects
2) Completely corrects
What disorder is characterized by a defect in GPIb/V/IX (CD42), shows LARGE platelets with pseudonucleolus, has impaired ristocetin aggregation?

Bernard Soulier

What does Bernard Soulier show on flow cytometry?
Decreased CD42a, CD42b and CD42d
(which corresponds to GPIb, V, and IX)
What disorder is characterized by a platelet aggregation problem because platelets can’t bind fibrinogen and this is from abnormal GP IIb-IIIa receptor?
Glanzmann thrombasthenia
What platelet disorder shows impaired ristocetin aggregation on PFA?

Bernard Soulier
What platelet disorder shows impaired aggregation with ADP, collagen and epinephrine but NORMAL ristocetin?

Glanzman thrombasthenia
What are the flow cytometry findings in Glanzmann thrombasthenia?
Decreased CD41 and CD61
(corresponds to GPIIb and GPIIIa respectively)
What is the main differential with Glanzmann thrombasthenia and how do you tell them apart?
Glanzmann and Afibrinogenemia
*Glanzmann’s has normal PT and PTT
Afibrinoginemia has increased PT and PTT
What disorder is has giant platelets AND WBC inclusion, is autosomal dominant mutation in myosin heavy chain 9 gene, has thrombocytopenia but very little bleeding and normal PMN function?
May Hegglin Anomaly
What is the mutation in May Hegglin anomaly?
Myosin heavy chain 9 gene













